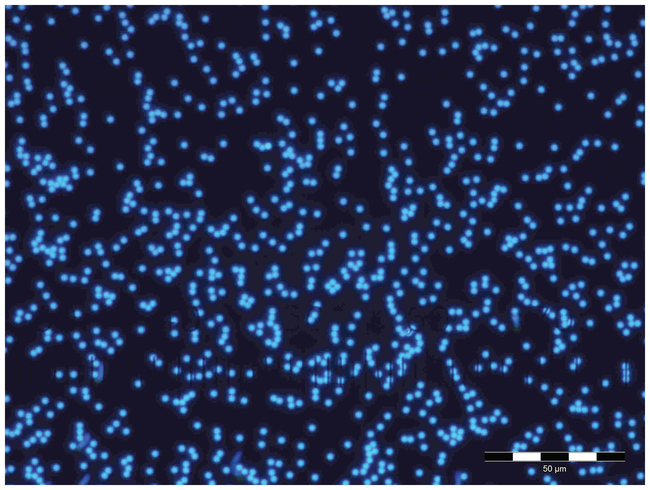

Search Fisher Scientific
Thermo Scientific
Fluoro-Max Dyed Blue Aqueous Fluorescent Particles
Achieve improved sensitivity and detectability in analytical methods with internally dyed microspheres that feature bright, high-contrast colors.
| Catalog Number | Diameter (Metric) | Quantity |
|---|---|---|
| TSSB0200B | 2 μm | 60 mL |
Catalog number TSSB0200B
Price (SGD)
-
Diameter (Metric):
2 μm
Quantity:
60 mL
Achieve improved sensitivity and detectability in analytical methods with Thermo Scientific™ Fluoro-Max Blue Aqueous Fluorescent Particles, internally dyed microsphere suspensions that feature bright, high-contrast colors.
Fluoro-max fluorescent particles emit bright and distinct colors when illuminated by the light of shorter wavelengths than the emission wavelength. This improves their contrast and visibility relative to background materials. These internally dyed polymer particles utilize the exclusive Firefli™ process to incorporate the dye throughout the polymer matrix to produce bright fluorescent colors, minimize photo bleaching and prevent dye leaching into aqueous media.
Spectral information is approximate and for reference only. The spectral properties of the dyes are dependent on their concentration and physical environment.The exact excitation and emission maxima may vary depending on the size and composition of the particles.
- Made of polystyrene (PS)
- Density of 1.05 g/cm3 and a refractive index of 1.59 @ 589nm (25°C).
- Packaged as 1% solids
- Can be detected with an epifluorescence microscope, confocal microscope, fluorometer, fluorescence spectrophotometer or fluorescence activated cell sorter
- Can also be detected using mineral light or black light (UV)
Spectral information is approximate and for reference only. The spectral properties of the dyes are dependent on their concentration and physical environment.The exact excitation and emission maxima may vary depending on the size and composition of the particles.
Recommended for:
- Filter testing
- Flow tracing
- Biological research
Specifications
AdditiveTrace amounts of surfactant to inhibit agglomeration and promote stability
Concentration1% solids
ContentsDyed polystyrene microspheres in water
ColorBlue
MaterialPolystyrene
Product TypeFluorescent Particle
Dye TypeFirefli Fluorescent Blue (365,388,412/ 445,445,473)
IncludesPackage Insert Sheet
Particle Density1.05g/cm³
Quantity60 mL
Refractive Index1.59 at 589nm (25°C)
StabilityProduct stable for a minimum of 24 months
Uniformity<5%
Diameter (Metric) Mean2 μm
Diameter (Metric) Nominal2 μm
Diameter (Metric)2 μm
Unit Size
Contents & Storage
Unless otherwise stated, refrigerate (2° to 8°C) product when not in use but do not freeze. Store upright and keep bottle tightly sealed. Mix product with gentle inversion by hand or vortex mixer. Product comes with stir bar for continual mixing duriong sampling.